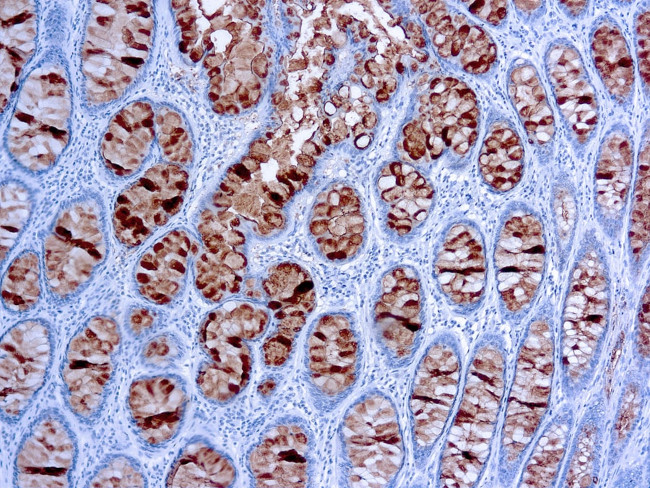
Colorectal Carcinoma Antibody in Immunohistochemistry (Paraffin) (IHC (P))

Search
Invitrogen
Colorectal Carcinoma Monoclonal Antibody (C241:5:1:4)
{{$productOrderCtrl.translations['antibody.pdp.commerceCard.promotion.promotions']}}
{{$productOrderCtrl.translations['antibody.pdp.commerceCard.promotion.viewpromo']}}
{{$productOrderCtrl.translations['antibody.pdp.commerceCard.promotion.promocode']}}: {{promo.promoCode}} {{promo.promoTitle}} {{promo.promoDescription}}. {{$productOrderCtrl.translations['antibody.pdp.commerceCard.promotion.learnmore']}}
产品信息
MA1-91152
种属反应
宿主/亚型
分类
类型
克隆号
抗原
偶联物
形式
浓度
保存液
内含物
保存条件
运输条件
RRID
产品详细信息
Recommended positive controls: Colon carcinoma.
This antibody reacts specifically with an epitope designated CA 19-9. It does not cross reacts with Lewis A and Lewis B. CA 19-9 has been shown to be useful marker in the diagnosis and management of gastrointestinal cancers.
靶标信息
This antibody is a marker for colon carcinoma's.
仅用于科研。不用于诊断过程。未经明确授权不得转售。